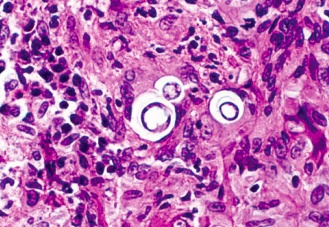

Fungi
Systemic Mycoses
_..
histoplasmosis
blastomycosis
coccidiodomycosis
paracoccidioidomycosis
Histoplasmosis
_..

Historian exploring cave
scene: Disease is spread by bats, especially in caves
map: endemic to midwestern/central U.S. along MS/Ohio river valley
coughing: Transmission through respiratory tract

_..

butterfly: Dimorphic: mold in cold, heat in yeast
macrophage cage: Histology of macrophage with intracellular oval bodies. KOH stain
puddle: Macrophage with histoplasma inside, smaller than both RBC/macrophages
red stone drip: Serum rapid antigen test
yellow stone drip: Urine rapid antigen test


_..

wall in the back: lung fibrosis and calcification
book with TB cacti: Histoplasma may mimic tuberculosis in presentation
Hilar calcifications: on Xray
coughing: pneumonia
pale stones on right with red dots: Erythema nodosum

_..

cane: Disseminated disease occurs in immunocompromised states
bull with spots: Hepatosplenomegaly (prevalent with macrophages)
_..

pinecones: Local or mild infections are treated with "-conazoles"
amphibians frog under cane: Systemic or disseminated infections are treated with amphotericin
Blastomycosis
_..

Blast of cannons
Valley scene and map: Geographic distribution: Great Lakes + Ohio River Valley (more on east coast)
soldier inhaling smoke: Transmission: Inhalation of aerosolized spores
Great lakes


_..

Dimorphic butterfly: Yeast in heat, mold in cold
fused cannon balls: Broad based budding, same size as red blood cell
yellow river: Detection via urine antigen test

_..

lung with cannon balls: Chest X-ray has patchy alveolar infiltrates/haziness
cannon balls in lung: Lesions or cavities in lungs

Systemic:
statue with craters in chest and rod exposed in leg: Systemic disease affects the SKIN and BONES
Bone involvement: osteomyelitis
cane: Immunocompromised
_..

pine cones on side with nonimmunocompromised solder: Itraconazole for local infections
frogs around statue: Amphotericin for disseminated infections
Coccidioidomycosis
_..

Presidio: coccidio
San juaquin: aka san juaquin fever
map and scene: Distribution: Southwestern United States
dust: Route of transmission: inhalation of spores in dust
cracks in ground: Earthquakes are a risk factor for infection

_..

butterfly: Cocci is dimorphic. Mold in cold but spherule in body
red spores in tumbleweeds: Cocci forms spherules filled with endospores inside lungs
smaller red hat next to tumbleweed: Cocci spherules are larger than red blood cells


_..

solder sweating, coughing, on ground: Clinical manifestation may look like an acute pneumonia: cough, fever and arthralgias
lung wall holes, bricks caved in/out: Radiographic images may show either nothing or cavities and/or nodules.
pillar resembling shins: Cocci is associated with erythema nodosum (only with healthy people, robust immune response)
cracked skin/leg: Skins and lungs are common sites of infection
May disseminate to the bone in immunocompromised patients
guy holding head: Meningitis may be seen in immunocompromised if cocci disseminates to the meninges. Headache/stiff neck
cane: Immunocompromised

_..

pinecones: Local lung infection treatment: conazoles
amphibian frog: Systemic infection treatment: Amphotericin B
Paracoccidioidomycosis basiliensis
_..

paracocci: pirates
map: Geographical distribution: South America
_..

butterfly: Dimorphism
captain's wheel: Yeast form looks like a "Captain's Wheel". Yeast in body (heat)
red center of wheel compared to wheel: Bigger than a red blood cell

_..

coughing: Transmission: respiratory droplets
white beads: Cervical lymphadenopathy, moves downward
circular medallion: Progresses to lungs, causing granulomas in lungs
poor dentation: Mucocutaneous lesions, ragged borders with small hemorrhage

_..

pinecone: Itraconazole for mild infections
frogs: Amphotericin for serious infections
Cutaneous Mycoses
_..
malassezia furfur
dermatophytes
sporothrix
Malassezia furfur
_..

malassezia italian restaurant
versi di colore sauce: causes Pityriasis Versicolor
woman wearing fur coat: furfur

"Spaghetti and meatball" appearance on KOH prep of skin scrapings

.,
_..

heat lamps to keep food warm: Flourishes with heat, humidity and sweating
_..

sauce on chef back and chest: Pityriasis versicolor: hypo- and hyper-pigmented skin patches, located on back and chest (in sun)

broken bottle of olive oil: Lipid degradation produces acid that damages melanocytes
corns on top layer of cake: Confined to the stratum corneum, the most superficial layer
_..

baby with spaghetti: Association of Malassezia fungemia in neonates (in NICU) receiving lipid infusions or TPN through catheters, cause sepsis/thrombocytopenia
_..

stain glass window with blue sun: Treatment with topical selenium sulfide, also known as Selsun Blue, proding corneum shedding
Dermatophytes
_..

T, E, M boys: Trichophyton, Epidermophyton and Microsporum
_..

tin man: Dermatophytes cause tinea, rarely invade
naked: Dermatophytes infect the skin
tin man scratching: Pruritic lesions
aka ring worm because looks like rings of rusts
rust on head: Tinea capitis is on the head/scalp
Tinea corporis is on the body
Tinea cruris is in the groin, also known as "jock itch"
Tinea pedis is on the foot, also known as "athlete's foot"
Also nails



_..

athletic headband: athletes, swimmers walking barefoot, wrestlers at risk
dog: Animals can be a source of transmission
_..

sprinkling salt: Diagnosed with KOH prep of skin scrapings
lamps in woods in trees: "Wood's lamp can be used to diagnose Microsporum "
_..

pine cones: Treat tinea with topical -azoles
_..

wizard of oz: Dermatophytes can also cause onychomycosis (nail infections)
Turban: Terbinafine treats onychomycosis
can of grease: Griseofulvin treats severe onychomycosis, likes to deposit in keratin tissues. GI SE
Sporothrix schenckii


.,
butterfly: Dimorphic
smoking gardner: Sporothrix look like cigar shaped yeast under a microscope
branching rose stems: Hyphae are thin and branched, at 25 C

rose buds: causes "rose gardener's disease".,

_..

green area: Fungus commonly found on tree bark, bushes and other plants
Spores introduced into body by cuts and wounds
_..

vines ascending. Vines travel up arm lymph: Infection spreads in an ascending pattern along the path of draining lymphatics. Looks like red bumps on skin

_..

pinecones: Itraconazole is the drug of choice to treat lymphocutaneous sporotrichosis
KI pesticides: Saturated solution of potassium iodide may also be used to treat lymphocutaneous sporotrichosis
Opportunistic
_..
candida
aspergillus
cryptococcus
mucor
PCP
Candida Albicans
_ is an opportunistic dimorphic fungus that grows as budding yeast cells, pseudohyphae, true hyphae, or spores. Pseudohyphae are distinguished from true hyphae by the lack of cytoplasmic connection between cells and relative frailty..
For most dimorphic fungi, the mnemonic "mold = cold, yeast = heat" applies. C. albicans is unusual because the mold form grows at 37°C while the yeast form (pseudohyphae and budding yeasts) predominates at 20°C.
Butterfly morphs

Germ tube test
_A diagnostic test where a sample of fungal spores are suspended in serum and examined by microscopy for germ tubes, which is an outgrowth produced by spores from fungi during germination. A positive germ tube test is strongly indicative of C. albicans..
Germ tube= true hyphae
Snow cones at 37, ice balls at 20
_..
Normal mold = hyphae = cold yeast = budding = hot
Candida mold = hyphae = hot yeast = budding = cold

Normal habitat
_Found in the mucous membranes of respiratory, GI, and female genital tracts, with tendencies to overgrow in warm, moist areas..
Part of the normal flora may contaminate sputum cultures
Overgrowth
_Can lead to:
Oral thrush of the mouth that appears as a white exudate on mucous membranes.
Vaginitis that presents with itching, copious secretion, and “cottage cheese” appearing clumps.
Cutaneous candidiasis can present as a beefy red rash with satellite pustular lesions in moist intertriginous areas (where two skin areas touch) such as under the breasts, axilla of the arm, or anogenital region. This can also manifest as a diaper rash in infants.
Red diper. Heat and humidity.
Immunocompromised or steroid usage
KOH: used for scraping prep
Adult scraping the snow..
Oral candidiasis risk
_Use steroids: Little boy with blue steroid inhaler
Use steroids without rinsing the equipment..
Vaginitis risks
_..
Candies: diabetes
Drugs: Antibiotics
Birth control pills all risks for candida
Teacher getting hit:
_Vaginitis typically presents with a normal vaginal pH less than 4.5 versus bacterial vaginosis or trichomonal vaginitis, where vaginal pH may be higher than 4.5..
Open until 4pH
_Oral thrush presents as white plaques that can be removed or scraped away. Contrast this with hairy leukoplakia, a manifestation of EBV also present in AIDS patients, which presents as white plaques on the side of the tongue that cannot be scraped off..
_In immunocompromised individuals, persistent infection can spread and lead to esophagitis and disseminated candidiasis, which may lead to infective endocarditis..
Pink slides with white snow. Pseudomembrane formation
Endocarditis
_.. 3 mountains with hearts: tricuspid valve
Commonly seen in IV drug users (in heroine)
First valve drug goes to
_Candida esophagitis presents as retrosternal pain upon swallowing is considered an AIDS-defining illness. Oral thrush is not considered AIDS-defining. Starts seeing at CD4<100
Max 100 lbs..
_T-cell deficient patients are more likely to get superficial Candida infections, whereas neutropenic patients are more likely to have disseminated candidiasis (hematogenous).
Catalase positive cat. CGD: disseminated..
Treatment
_Treatment include:
Nystatin mouthwash and oral fluconazole for thrush and esophagitis
Topical azoles or oral fluconazole for vaginitis
Oral fluconazole or any IV echinocandins for disseminated candidiasis. Pinecones for conazoles Play Nyce for oral Frogs, amphibians for immunocompromised Cap on elderly: capsofungin for immunocompromised..
Aspergillus fumigatus
_..

asparagus farm with plane spraying fumes: aspergillus fumigatus
_..

cat: Catalase positive
peanut plant with acute angle with septations: Aspergillus hyphae form acute angles and have septations
ASpergillus: A for acute. S for septation
peanut plant yellow flower with stalks: Transmission: inhalation of conidiophores, which are "fruiting bodies"


_..

peanut plant, wheat field: Aflatoxins, toxins produced by Aspergillus flavus, are associated with peanuts and grain crops
cow with liver spot in front of crab : Aflatoxins may cause hepatocellular carcinoma
corn, soybean
_..

hepatocellular carcinoma from aflatoxin
ABPA, allergic bronchopulmonary aspergillosis
aspergilloma
disseminated aspergillosis
_..

plane with letters. Farmer running/migrating, sweating, inhaler in hand: ABPA (allergic bronchopulmonary aspergillosis) is a type I HSR that causes wheezing, fever and migratory pulmonary infiltrates. Also association with CF patients
IgE on inhaler: ABPA is associated with asthma and may show increased IgE levels in the serum
_..

farmer on left. Cactus: fungus balls. Aspergillomas form in cavities, such as in TB/klebsiella cavities. People with cavities in lungs already are at risk
peanuts underground: Aspergillomas are gravity-dependent, fungus at bottom of cavity on chest xray


_..

Farmer with cane: Angioinvasive aspergillosis: Immunocompromised. Pts with neutropenia from leukemia/lymphoma
sprinklers look like vasculatures: Disseminated aspergillosis is angioinvasive. Invades blood vessels and disseminates throughout whole body
farmer coughing/fever/hemoptysis: symptoms
scarecrow with spots at kidney, heart, head black spot with ring: Renal failure
Endocarditis
Ring-enhancing brain lesion (seizures, focal neuro deficits, with symptoms)
black nose: Paranasal sinus necrosis, necrosis around nose, also seen in mucor

_..

pinecones and vortex: Use voriconazole for aspergillus infections, also surgery removal
frogs: Use amphotericin for serious infections
Cryptococcus neoformans
_..

Egyptian crypt for cryptococcus
coffins: Yeast are round and heavily encapsulated
repeating pattern on coffin: Cryptococcus capsule has a repeating polysaccharide capsular antigen. Main virulence factor for antiphagocytes
NH3 spray bottle: Urease positive
_..

pigeons with droppings. Archaeologists coughing: Cryptococcus is inhaled from soil and/or pigeon droppings. Settles in lungs
cane: Immunocompromised (HIV)
_..

archaeologists coughing: Pulmonary Crypto causes cough and dyspnea
Neck brace: Can cause cryptococcosis, a fungal meningitis. Most common cause of fungal meningitis
sweating: fever
_..

soap bubbles on lung: Diagnose with a microscopic exam of bronchopulmonary washing
red and silver stripes: Diagnosis of pulmonary Crypto can be aided by mucicarmine or methenamine silver stain
vase with bubbling tar: India Ink test can diagnose Crypto meningitis with lumbar puncture/CSF. Background dark, transparent organism
latex gloves next to repeating patterns: Latex agglutination test detects polysaccharide capsular antigens and causes their agglutination

soap bubbles on head: Causes "soap bubble" lesions in gray matter



_..

frogs, pinecone, with flute: flucytosine/amphoterecin B joint treatment with maintenaince fluconazole
Mucormycosis
_..

Mu Car Rides: Mucor and Rhizopus
_..

cane: Immunocompromised. Leukemia/neutropenia
candy: Diabetic and neutropenic patients are at risk of developing Mucor infections
bread: Rhizopus is a bread mold
mechanic coughing, fumes: Transmission is through inhalation, proliferate in blood vessel walls where high glucose/ketones are
Ketone autoparts: Patients in DKA with a high ketone load are at risk of developing Mucor infections
_..

tire arm at 90 angles without sepate: Hyphae have wide-angle branching and are non-septate

_..

red jumper cables: Mucor proliferates in blood vessels
oil pan with holes: Penetrates cribiform plate and enters the brain, leading to rhinocerebral and frontal cortex abscesses
mechanic with oil on face: Necrotic tissue may present as black eschar on the face. Poor prognosis

_..

car is a frog: Treat with surgery and amphotericin
Pneumocystis pneumonia
_..

ping pong: 2 P's, PCP
Aid for aids: PCP, caused by Pneumocystis jiroveci, is an AIDS-defining illness
20 to 0: Increased risk of infection when CD4 count < 200
respiratory transmission
_..

cane and coughing: Causes symptoms in immunocompromised people
no cane, no symptoms: Asymptomatic in healthy individuals
Causes cough, dyspnea and fever. Not productive like bacteria
_..

glass tables with cracks: "Ground glass" appearance on chest X-ray
BAL bottle: Diagnose infection with bronchoalveolar lavage (BAL) sample, easier than lung biopsy
silver disks at center of table: Use methenamine silver stain on tissue sample to help with diagnosis
ovoid ping pong: Yeast are ovoid shaped on silver stain


_..

Back hand: Bactrim, or TMP-SMX, can be used as prophylaxis and treatment
jar of pin pong balls that look like eggs: Sulfonamides (part of Bactrim) are used for prophylaxis/treatment
pentagon paddles: Pentamidine is an alternative drug used for prophylaxis and treatment
Last updated
Was this helpful?